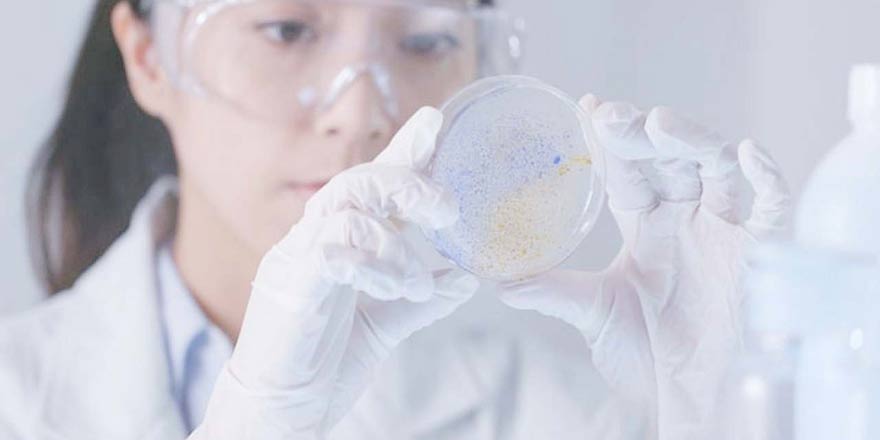
teknoloji.jpg

Teknoloji kısır bırakıyor
Çocuk sahibi olmak isteyen yaklaşık 7 çiftten biri, ne yazık ki çocuk sahibi olamıyor ve bu çiftlerin de yaklaşık 3'de 1'inde sorun yalnızca erkek kaynaklı oluyor. Selçuk Üniversitesi Tıp Fakültesi Hastanesi Üroloji Bölümü Dr. Öğretim Üyesi Ali Furkan Batur, kısırlığın, teknolojiyle doğru orantılı olarak arttığını söyledi.
Çocuk sahibi olmak isteyen yaklaşık 7 çiftten biri, ne yazık ki çocuk sahibi olamıyor ve bu çiftlerin de yaklaşık 3’de 1’inde sorun yalnızca erkek kaynaklı oluyor. Selçuk Üniversitesi Tıp Fakültesi Hastanesi Üroloji Bölümü Dr. Öğretim Üyesi Ali Furkan Batur, kısırlığın, teknolojiyle doğru orantılı olarak arttığını söyledi.

Son dönemde yapılan araştırmalara göre, çocuk sahibi olmak için tedavi gören çiftlerin sayısı günden güne artıyor! Üroloji Bölümü Dr. Öğretim Üyesi Ali Furkan Batur, bir çiftte kısırlık problemi olduğunu söyleyebilmek için beklenmesi gereken sürenin 1yıl olduğunu ama bu sürenin Dünya Sağlık Örgütü tarafından yapılan çalışmalar neticesinde 2 yıla çıkarılması planlarının olduğunu söyledi. Günümüzde teknoloji kullanımının artmasıyla kısırlığın da arttığının altını çizen Batur, “Günümüzde, teknoloji ekipmanlarının kullanımının artmasıyla beraber elektromanyetik alanın yarattığı bir olumsuz etki mutlaka var. Çok sık dizüstü bilgisayar kullananlarda sperm parametrelerinde azalmalar çok görmekteyiz. Bir de günümüzde beslenmemiz tamamen doğal dışı kaynaklara kaydı. Gıda maddeleri içinde kullanılan yapay maddeler, katkı maddeleri, hormonlardan dolayı, tabi ki kısırlık veya daha doğrusu sperm sayılarındaki düşüşler arttı” dedi. Dr. Ali Furkan Batur, kısırlığı, “Evli bir çiftin veya çocuk sahibi olmak isteyen bir çiftin bir yıl süreyle korunmasız ve uygun cinsel ilişkide bulunmasına rağmen çocuk sahibi olamaması veya daha doğrusu gebelik gerçekleşmemesi durumudur” şeklinde tanımladı.

YÜZDE 10 ORANINDA KISIRLIK GÖRÜLÜYOR”
Toplumda kısırlığın ne sıklıkla görüldüğünü anlatan Batur, “Toplumuzda yaklaşık %5-10 oranında kısırlık görülüyor. Biz ürologlar olarak kısırlık değerlendirmesinde erkek tarafını değerlendiriyoruz. Kadın tarafını kadın doğum doktorları değerlendiriyorlar. Bizim toplumumuzda problem tamamen kadındaymış gibi bir algı var. Aslında bir çift çocuk sahibi olamıyorsa, yüzde 30 ihtimalle bundan erkek sorumludur. Yüzde 30 ihtimalle kadın sorumludur. Yüzde 40 ihtimalle ise her ikisi birden sorumludur” diye konuştu.
BAZI KISIRLIK TÜRLERİNİN TEDAVİSİ YOK
Kısırlığın bir tedavisinin olup olmadığından bahseden Dr. Ali Furkan Batur, “Kısırlığın, tedavisi olan ve olmayan nedenleri vardır. Bazı azospermik durumların tedavisi olmayabiliyor. Biz erkek tarafını değerlendirdiğimiz zaman yüzde 15-20 ihtimalle varikosel denilen bir rahatsızlığa rastlıyoruz. Bu varikosel denilen hastalık temel olarak erkeklerin özellikle de sol yumurtalarında(testiste) olmak üzere venlerin genişlemesiyle sperm parametrelerini olumsuz olarak etkiliyor ve erkeklerde çocuk sahibi olamamaya neden oluyor“ ifadelerini kullandı. Batur, sperm sayısının azalma nedeni varikosel rahatsızlığının ameliyatla bir tedavisinin mümkün olduğunu ve bunu da ürologlar olarak kendilerinin gerçekleştirdiğini sözlerine ekledi.
“KISIRLIK GİTTİKÇE ARTIYOR”
Çocuk sahibi olamayan çiftlerin çoğunlukla ilk önce kadın doğum bölümüne başvurduklarını aktaran Batur, “Oradan bize yönlendirilen hasta sayısı ise gün geçtikçe artıyor. Son 10 sene içerisinde bu hasta sayısı oldukça arttı. Tedavisi gerçekleştirilenler var, gerçekleştirilemeyenler var. Bir de işin tüp bebek boyutu var. Tedavisi ilaçlarla ve cerrahi yöntemlerle mümkün olmayan çiftlerde tüp bebek tedavisi de olumlu sonuçlar veriyor.” şeklinde konuştu.
“İLK ÖNCE ERKEK TARAFININ DEĞERLENDİRİLMESİ LAZIM”
Kısırlık şikâyetiyle gelen çiftlerde ilk önce erkek tarafının değerlendirilmesinin önemine değinen Batur şöyle konuştu: “Kadın tarafını değerlendirilirken yapılan tetkikler girişimsel işlemler oluyor ve nadiren de olsa kadınlarda bir takım sorunlara neden olabiliyor. Kadınların tüplerinde de yan etkilere neden olabiliyor. O yüzden kısırlık sorunu olan çiftlerde ilk önce erkeklere bakmak ve sperm tahlili yapmak daha uygun. Bir de yüzde 15-20 oranında görülen varikosel için skrotal renkli doppler ultrasonografi dediğimiz yumurtaların kanlanmasının kontrol edilmesi tetkiki var. Bu tetkiklerle beraber erkeğin genel durumunu ve hormonal değerlendirmesini de yaptıktan sonra hastanın bulunan rahatsızlığına göre uygun hedefe yönelik tedavi yapılabilir. Eğer bu tetkiklerde erkekte problem çıkmaz ise o zaman kadının değerlendirilmesi gerekmektedir.”
“BİR TAKIM GENETİK NEDENLER VAR”
Kısırlığın bir takım genetik nedenlerinin olduğunu ve onların bir kısmının tedavisinin olmadığını kaydeden Batur, “Klinefelter hastalığı denilen bir sendrom ve AZF delesyonları, en sık görülen genetik problemler olarak karışımıza çıkmakta. Ne yazık ki bunların bir kısmının tedavisi olmamaktadır. Bu hasta grubunda da tüp bebek tedavisi ile çocuk sahibi olabilen çiftler olduğu gibi çocuk sahibi olamayan çiftler de bulunmakta. Son olarak Amerika’da yasal olan, ülkemizde yasal olmayan sperm bağışlarıyla beraber hareket eden sperm bankaları var. Oradan alınan spermlerle döllenme yapılarak çocuk sahibi olunuyor ama kişinin kendi çocuğu olmuyor. İnsanlar çocuk sahibi olabilmek için bu yollara da tevessül edebiliyorlar” diyerek sözlerini tamamladı.
SÜMEYRA KENESARI/ YENİ HABER GAZETESİ
Bakmadan Geçme